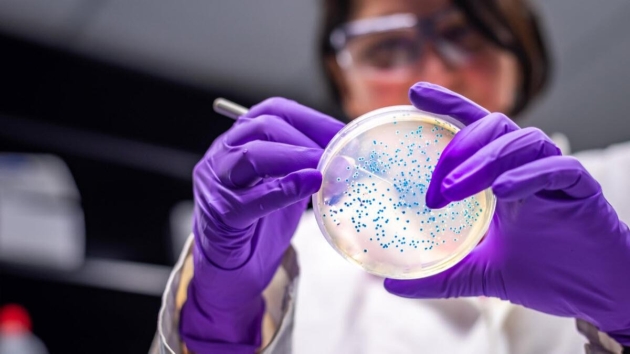

Harvard'lı Türk geliştirdi! Hedef yılda 1 milyar dolarlık ihracat
Yayın Tarihi: 26 Aralık 2021 Pazar 10:00:00
Güncelleme Tarihi: 26 Aralık 2021 Pazar 09:42:00
Harvard'da araştırmalar yaparken tası tarağı toplayıp Türkiye'ye dönen Dr. Serdar Uysal, Türkiye'yi endüstriyel enzimde bölgesel üs yapacak bir yatırıma imza attı. Tesis, yılda 150 milyon dolarlık ithalatı frenleyecek.
Akşam Gazetesi

Harvard ve MIT gibi Amerika'nın en iyi okullarında 13 yıl eğitim gördükten sonra Türkiye'ye dönerek, mesleki birikimini ülke için değerlendirme kararı alan Türk girişimci ve akademisyen Serkan Uysal, ülkenin ilk endüstriyel enzim fabrikasını kurdu. Tuzla Deri Organize Sanayi'de 4 bin metrekare kapalı alana sahip LIVZYM Biyoteknoloji, Türkiye'nin hali hazırda yurtdışından ithal ettiği endüstriyel enzimi yurtiçinde üreterek, yıllık 150 milyon dolarlık ithalatın önüne geçecek. Dünyada 10 milyar dolarlık endüstriyel enzim pazarı olduğuna dikkat çeken başarılı girişimci Uysal, "Bunun 2 milyar dolarlık kısmı Türkiye'nin de içinde bulunduğu bölgede tüketiliyor. Bu fabrikayla amacım, hem Türkiye'deki sektörlere ithal ikamesi ürünler geliştirmek hem de Afrika, Rusya ve Orta Doğu'yu da içine alan geniş bir coğrafyaya yılda 1 milyar dolarlık ihracat yapmak" dedi.
PAZARI DOMİNE EDECEK
Türkiye'den Afrika'ya, Rusya'dan Orta Doğu'ya uzanan geniş coğrafyanın ilk enzim üretim tesisi olan LIVZYM, Özbekistan'a satış yapmaya başladı. Firma, şu sıralar Batı Avrupa'dan bir ülke ve Mısır'la satış anlaşması imzalamak üzere. Hayata geçirdikleri yatırımla Türkiye'yi bölgenin endüstriyel enzim üretim merkezine dönüştürmeyi hedeflediğini açıklayan Uysal, şunları kaydetti: "Önümüzdeki günlerde 80 milyon dolar değerleme üzerinden yeni bir yatırım turuna çıkıyoruz. Buradan beklediğimiz 8 milyon dolarlık gelirle fabrikamızı 6 kat büyütmeyi hedefliyoruz. Amacımız enzimde Türkiye'nin PETKİM'i TÜPRAŞ'ı olmak. Bölge pazarını domine edecek bu yatırım aynı zamanda 353 milyar dolarlık hacme sahip dünya biyoteknolojik ürün pazarından Türkiye'nin yeni yatırımlarla pay almasının da önünü açacak."
10 MİLYAR DOLARLIK PAZAR
Her canlının kimyasal tepkime yapabilmesi için ihtiyaç duyduğu biyomoleküller olarak tanımlanan enzimlerin görevi, hücrelerdeki tepkimeyi hızlandırmak. Gıdadan kağıt sanayiine, kozmetikten ilaca, tekstile kadar akla gelebilecek her alanda kullanılan enzimler, dünyada 10 milyar dolarlık bir pazar oluşturuyor. Sürdürülebilir ve çevre dostu ekonomiler ürünlerinde kimyasalları kullanmak yerine enzimleri tercih ediyor. LIVZYM'in üretim stratejilerinde öncelikli alanı gıda ve yem; yakın zamanda bu alanların genişlemesi ve şirketin piyasaya sunduğu enzim portföyünde 10 farklı enzime ulaşması planlanıyor.

TERSİNE GÖÇ BAŞLADI
Dr. Serdar Uysal, bir yandan enzim üretimi yaparken diğer yandan biyoteknoloji alanında insan kaynağı yetiştirmek için Bezmialem Vakıf Üniversitesi'yle hummalı bir çalışma içinde. Uysal, Beykoz'da 40 milyon TL'yi aşan yatırımla kurulan Yaşam Bilimleri ve Biyoteknoloji Enstitüsü'nde MIT, Stanford ve John Hopkins gibi dünyanın sayılı üniversitelerinde de görev alan 10 akademisyenle beraber Ar-Ge faaliyetlerine imza atıyor. LIVZYM'de biyoteknoloji alanında uzman insan kaynağının yetiştirileceğini vurgulayan Uysal, "Yetişmiş insan kaynağı ve kritik bilgi birikimi, gelecekte ülkemize benzer tesislerin kazandırılmasına katkı sunacak" dedi.




















